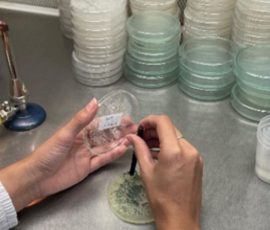
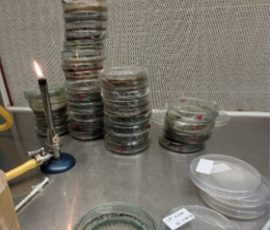
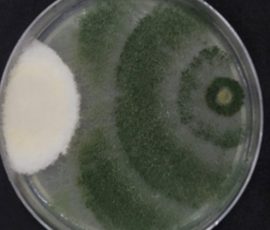
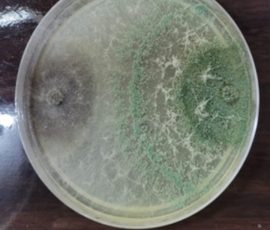

La becaria del Programa Universitario de Becas para la Investigación, «Andrés Borgognon Montero» (PUBIABM – 2.ª Cohorte 2025), Cecilia Cáceres (Ing. Agronómica – FCA/UNA), avanza en su trabajo final de grado titulado: “Bioprospección de aislados de Trichoderma spp. de la Región Occidental para el control biológico de Macrophomina phaseolina y Fusarium spp. en soja”, desarrollado bajo la tutoría del Prof. Adans Colman.
En ese contexto, los ensayos de confrontación in vitro entre Trichoderma spp. y los fitopatógenos Macrophomina phaseolina y Fusarium spp. concluyeron satisfactoriamente. Actualmente, las actividades del equipo de trabajo se concentran en los ensayos a campo con las cepas seleccionadas.
Esta investigación tiene como propósito evaluar el perfil antagónico de aislados de Trichoderma spp., obtenidos a partir de muestras de suelo de la Región Occidental, con el fin de analizar su potencial para el control biológico de Macrophomina phaseolina y Fusarium spp. en el cultivo de soja.
¡Éxitos, Cecilia, en este importante proceso de investigación!
PUBIABM: apoyando a jóvenes universitarios en la culminación de sus carreras de grado.